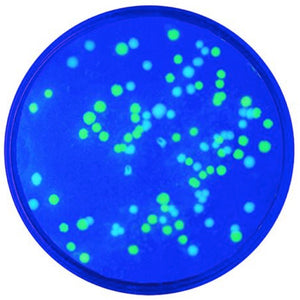

Collection: Transformation
-
Transformation with Green Fluorescent Protein - Edvotek 223

- Regular price
- £115.00
- Sale price
- £115.00
-
Transformation with Green & Blue Fluorescent Proteins - Edvotek 222
- Regular price
- £145.00
- Sale price
- £145.00
-
Transformation of E. coli with pGAL™ (Blue Colony) - Edvotek 221

- Regular price
- £119.00
- Sale price
- £119.00
-
Blue/White Cloning of a DNA Fragment & Assay of ß-galactosidase - Edvotek 300

- Regular price
- £259.00
- Sale price
- £259.00
-
Construction and Cloning of a DNA Recombinant - Edvotek 301

- Regular price
- £469.00
- Sale price
- £469.00
-
The Future of Biofuels - Alcohol Fermentation - Edvotek 304

- Regular price
- £155.00
- Sale price
- £155.00
-
Agar Art: Creating Masterpieces with Microbes - Edvotek 228

- Regular price
- £139.00
- Sale price
- £139.00












